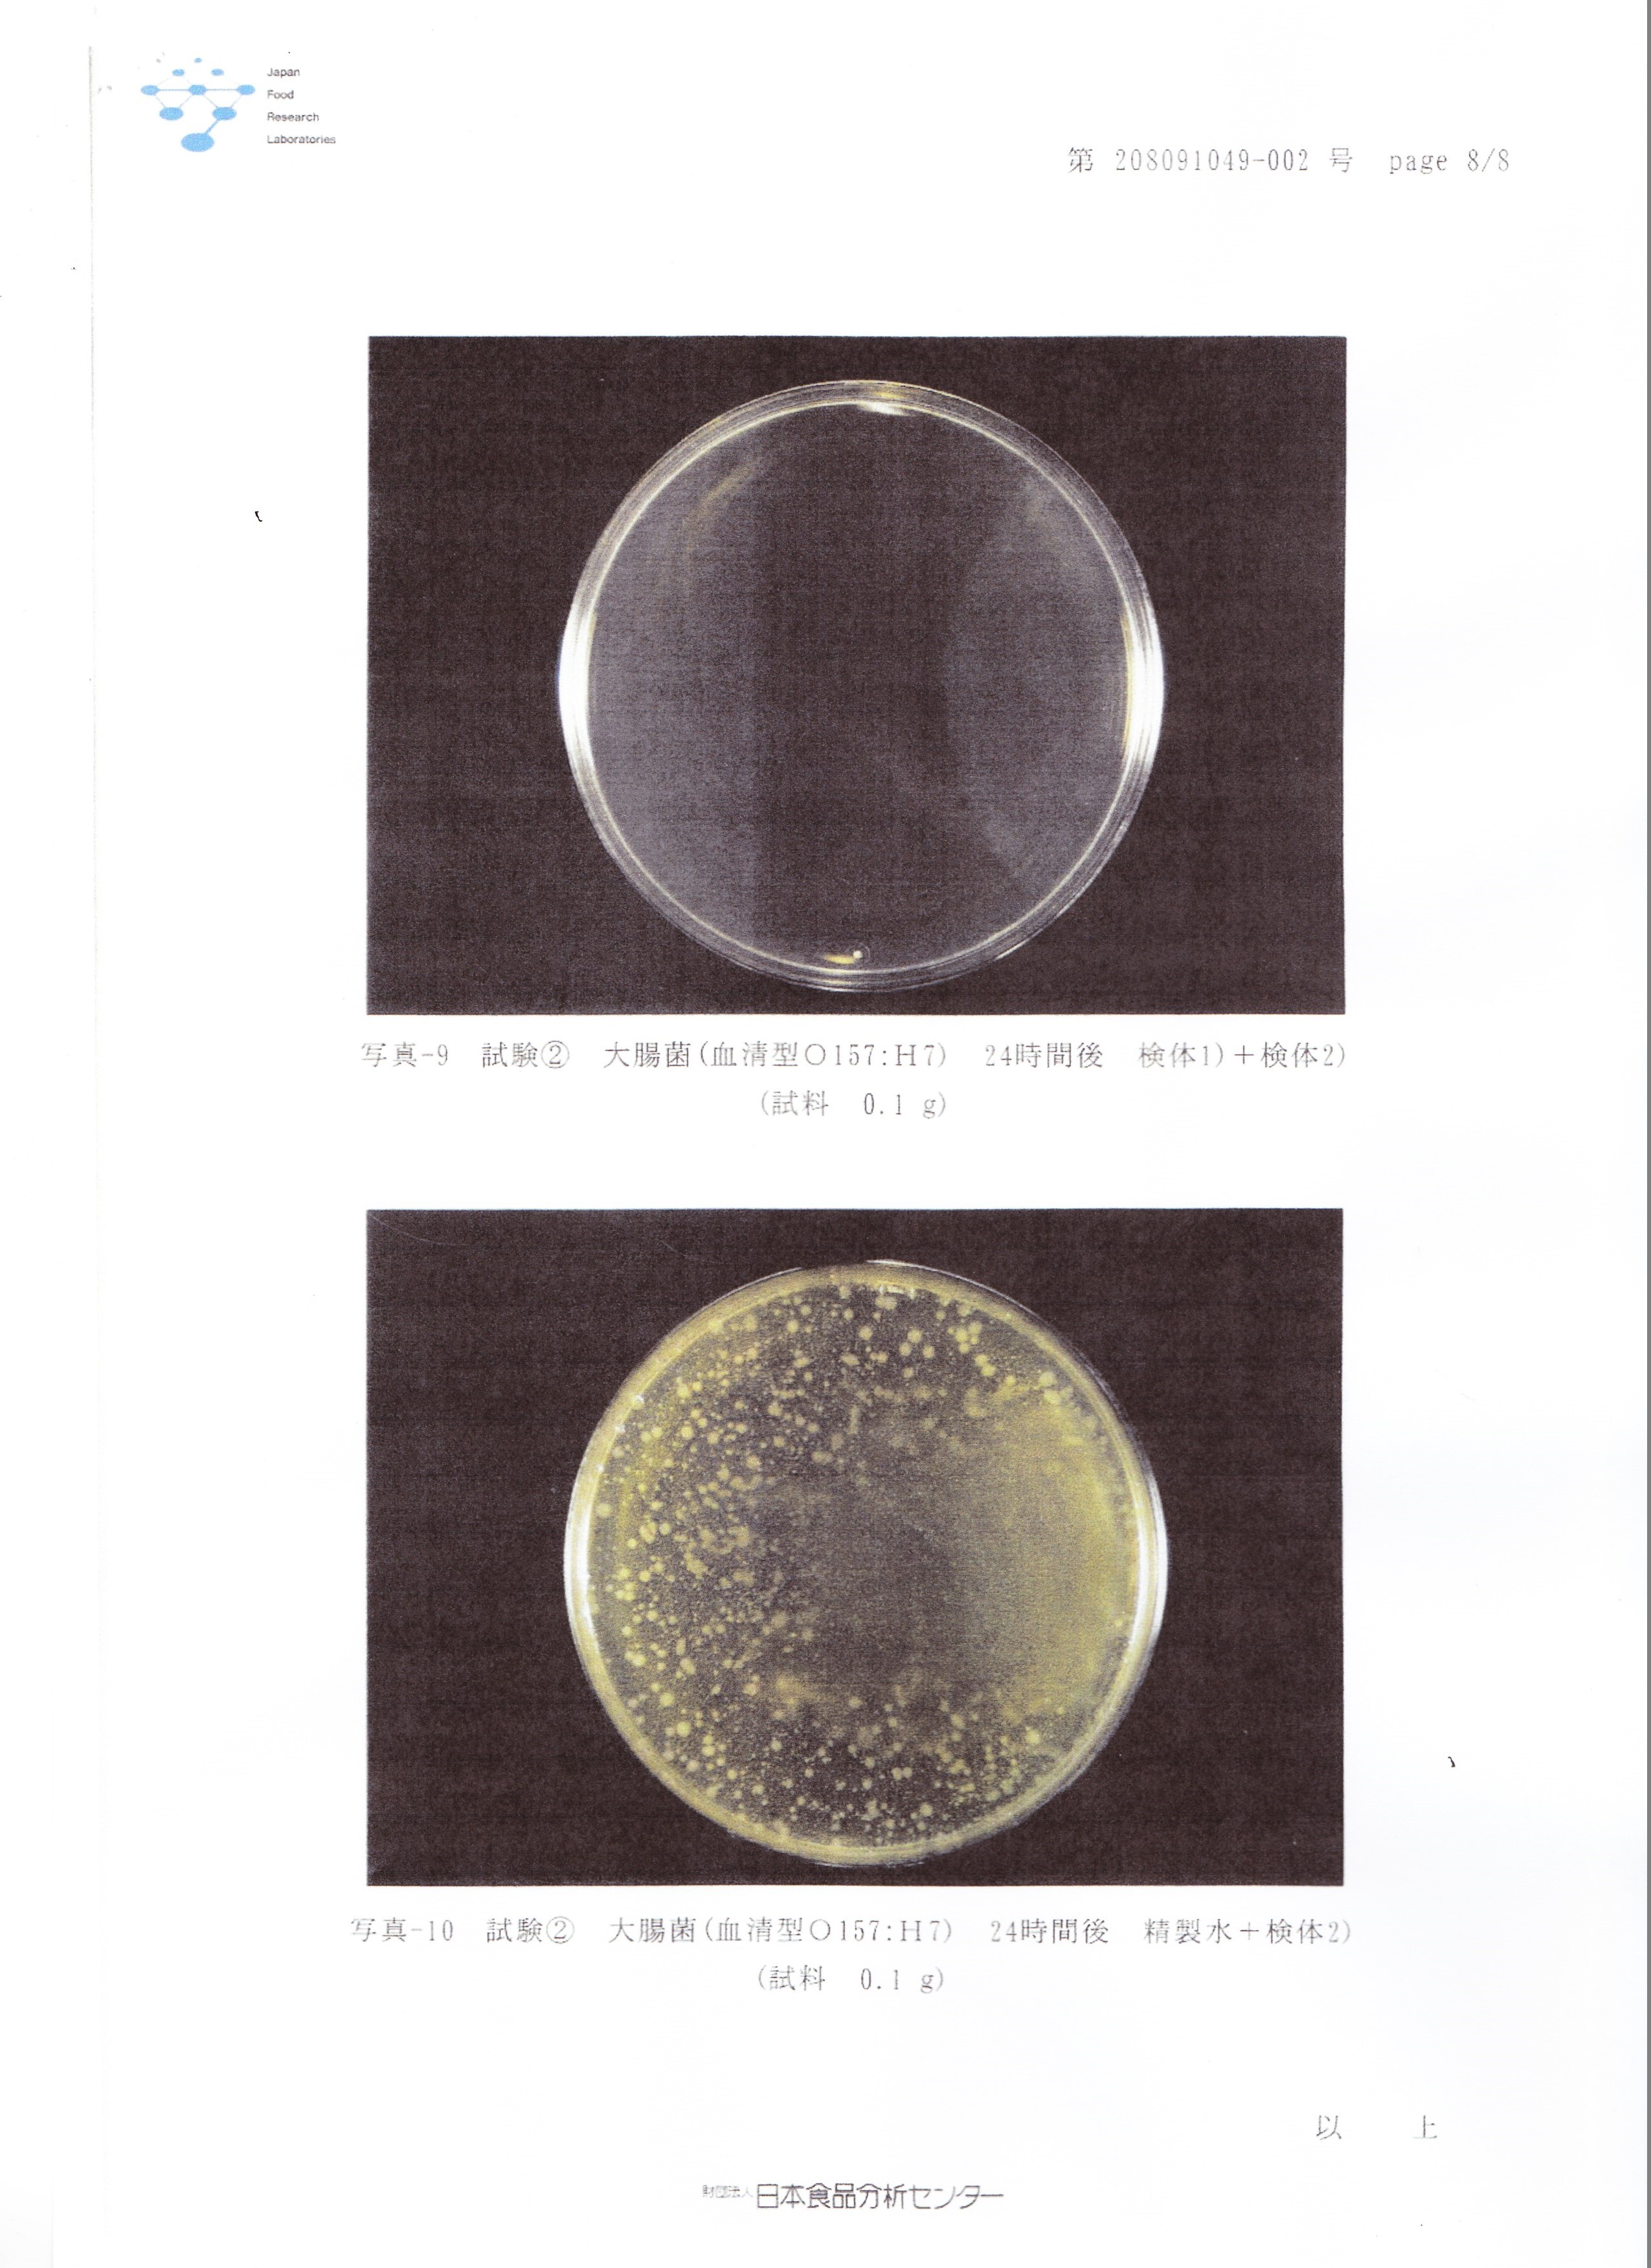

- 1、「E&S」は東北震災での被災地における「汚泥糞尿臭」「異臭悪臭」「環境保全」を前提に「瓦礫」から発生する「細菌の繁殖・増殖」を分解することに最善を尽くしました。
- 2、「瓦礫」の中には、人間と違い「酸素」がなくても増殖・繁殖する細菌が多く「発酵」という生き方があり、「E&S」は、その「発酵」にも立ち向かいい「強い菌(耐性菌)となる前に細菌を分解・消臭します。
- 3、「E&S」の最大の弱点は、アルコールや化学薬品を使用していませんので、殺菌するスピードが遅いですが、分解効力は、化学薬品を使用した消臭剤よりも数倍の効力を発します(特許取得・公的機関の検証実証済み)
- 4、下段にある「大腸菌」は日常生活に最も多く存在し、体内に入るとO-157などにも関連する驚異的な細菌ですが、「E&S」は完全に分解してしまいます…世の中に沢山存在する「消臭剤」と違うのは、「人工香料」でごまかす消臭剤 と「化学薬品で強行殺菌」する消臭剤に別れますが、「E&S」は弱酸性で人体にやさしく、日常生活から出る生活汚 泥・生ゴミ・異臭悪臭の根源である「細菌」を分解し、消臭するスグレモノであります。
- 5、検証実証を繰り返し「環境的な生活」「衛生的な日常」「次世代のための技術」として確立しつつ、日々研鑽しております。



![]()